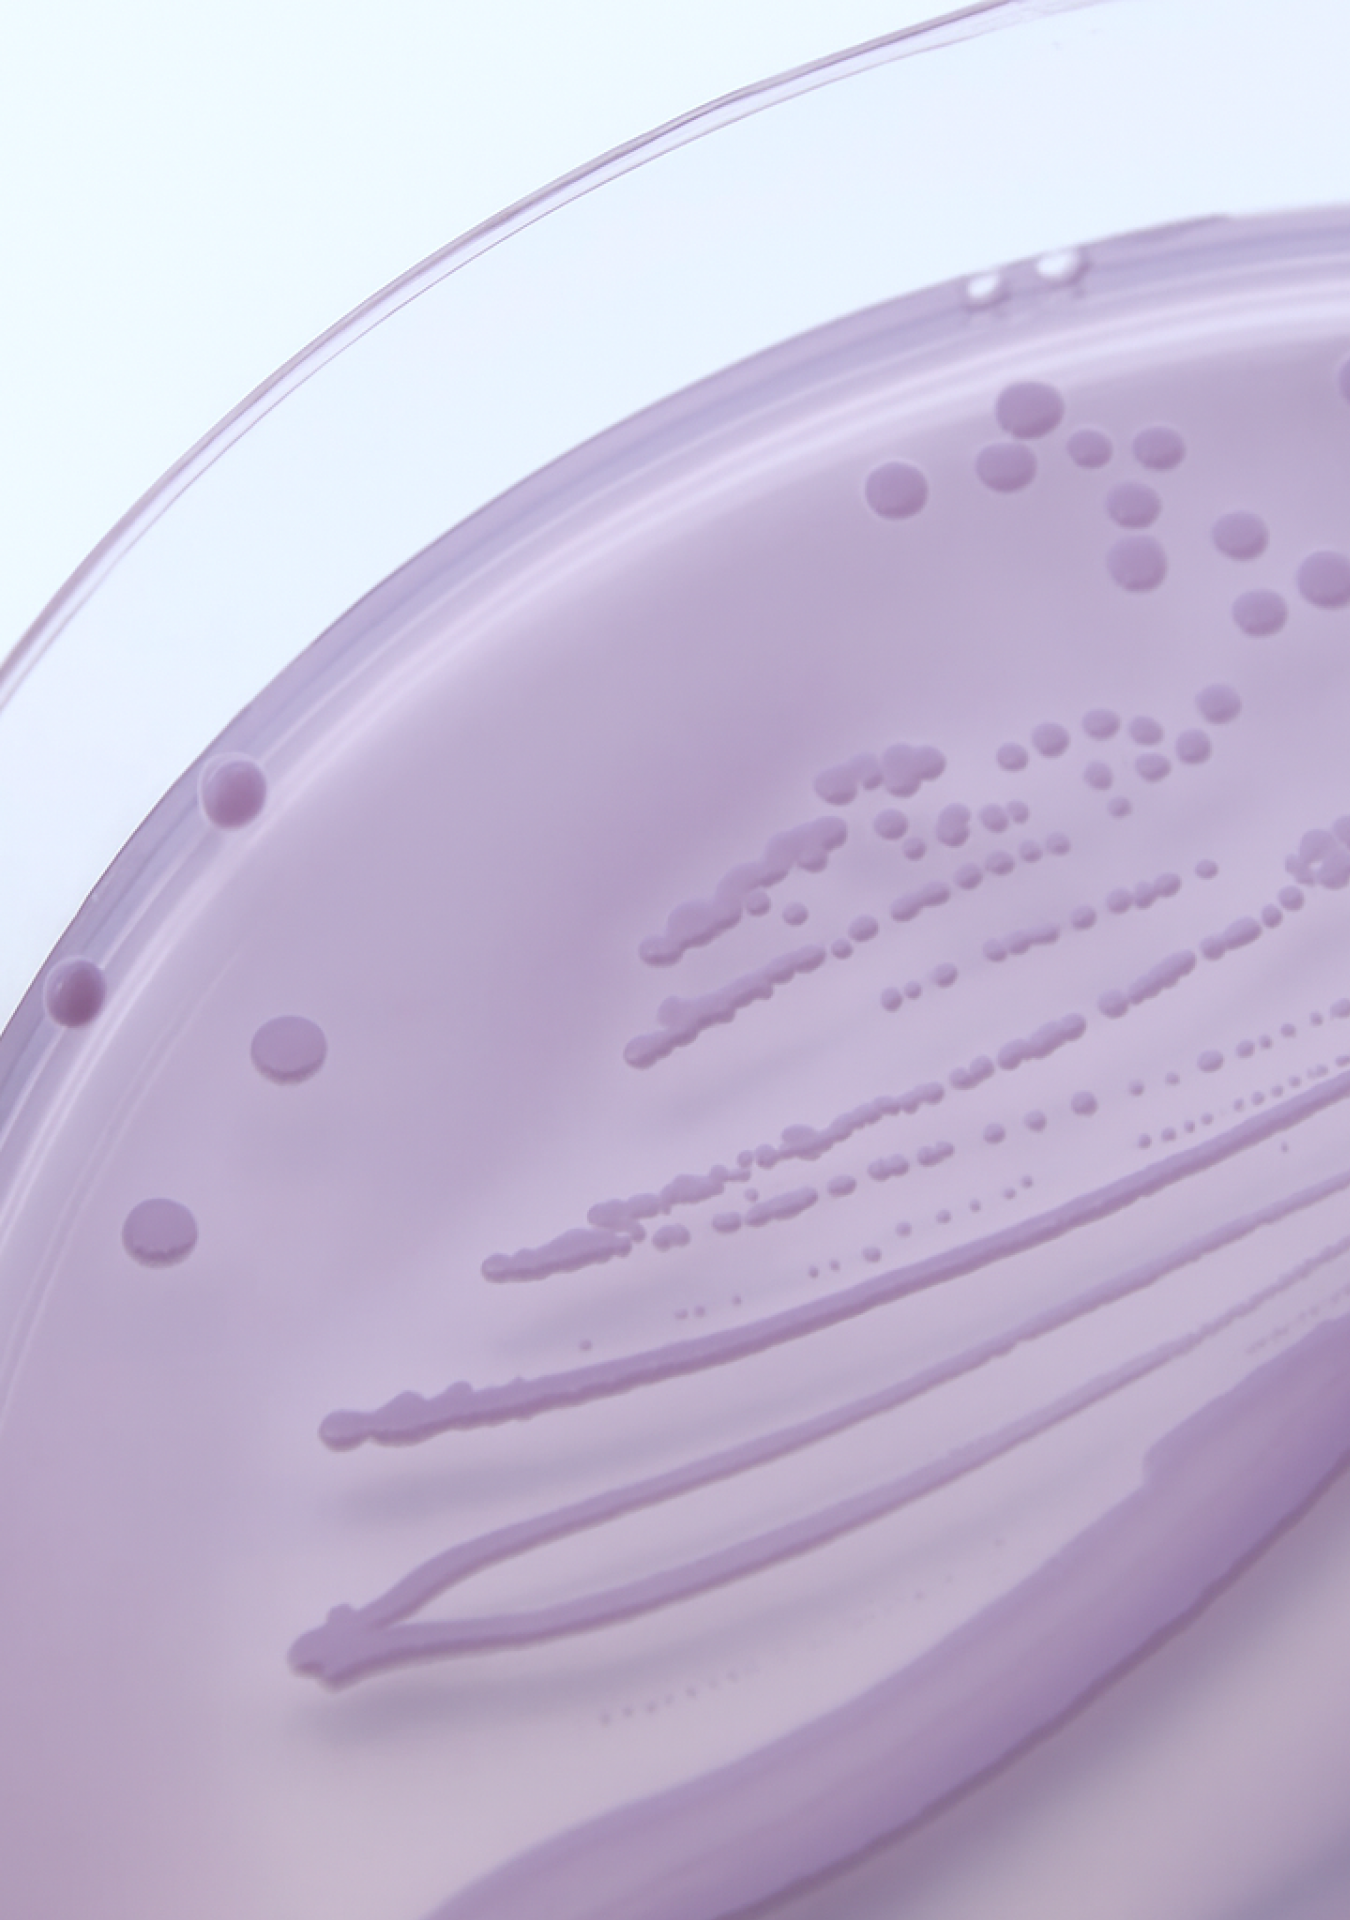

Your health, your call
Our science-backed UTI test gives you fast, accurate answers, so you can take action and feel better, sooner.
-
Catherine, QLD.
I’ve dealt with recurring UTIs for years, so having a reliable at-home test kit has become essential. The Health Alert UTI Test Kit exceeded my expectations! The instructions were super easy to follow, simple step-by-step directions that made the process stress-free. Highly recommend!
-
Jess, NSW.
As a mum to a daughter who gets frequent UTIs, the Health Alert UTI Test Kit has been a game-changer, easy to use, fast, and it helps us catch infections early before they get worse. It also saves us a trip to the doctors for preliminary testing.
-
Hilary, SA.
I recently used the Health Alert UTI Test Kit, and overall, I found it to be a convenient and reliable option for quick at-home testing.